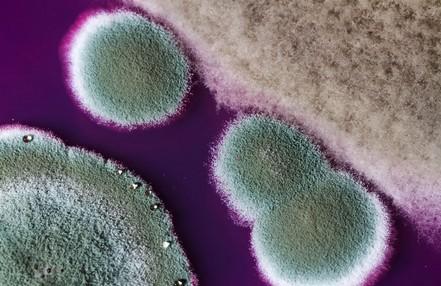

Asthma Friendly Schools Information for Parents


![]()




To enable schools and settings to achieve a set of quality standards for asthma care.
To ensure the safety of young people with asthma in school.

Achieve a standardised approach to asthma management in schools.
Less school days missed due to asthma.
Less hospital presentation due to poor management of asthma.
To understand the incidence of asthma and care requirements for your school setting.
Increased knowledge and confidence for staff in managing asthma in school
Increased knowledge and clear support for students.
Increased knowledge and confidence for parents.


Asthma is a long term health condition that affects the airways
It affects 1 in 12 adults and 1 in 11 children/young people - that is 2-3 students in each class.
When young people with asthma come into contact with a trigger, the muscles around their airways become tight and the lining of the airways becomes swollen and inflamed.
This causes narrowing of the air passage (imagine the diameter of a hose pipe reducing to a straw).
The development of mucus or phlegm further reduces the airway and the young person’s ability to move air in and out of the lungs, therefore making it difficult to breathe.

SMOKING

CHEMICALS

STRESS & EMOTIONS





FEATHERS

ANIMALS

• Asthma is a very common long-term lung condition.
• People with asthma often have sensitive, inflamed airways. They can get symptoms like coughing, wheezing, feeling breathless or a tight chest.
• Asthma symptoms can come and go. Sometimes people may not have symptoms for weeks or months at a time.
• Asthma needs to be treated every day, even if you feel well, to lower the risk of symptoms and asthma attacks.

Most young people with asthma take inhalers. They may also take tablets or granules.
There are 2 types of inhaler:

• PREVENTER IINHALERS stop asthma symptoms like coughing & wheezing happening.
• They need to be taken every day, even if your child feels well and their breathing is fine.
• They are normally brown or purple.
• RELIEVER INHALERS work to make asthma symptoms like coughing & wheezing better.
• They should only be taken when needed eg: if your child is coughing, wheezing or finding it difficult to breathe.
• They are normally blue.
• ALL INHALERS SHOULD ALWAYS BE TAKEN WITH A SPACER, unless your child is using a dry powdered device. Your doctor or asthma nurse will tell you if this is the case and it should be stated on their asthma plan.
• Older children should always have their reliever inhaler and spacer with them in school (in their bag or blazer pocket) and know who to go to for help if they feel unwell. Younger children should know where their inhaler and spacer are kept, and also know who to go to for help.











• How to use a spacer with tidal breathing | Asthma + Lung UK (asthma andlung.org.uk)





You don’t need to use a spacer with these devices, but it is important to know how to use them properly






• Young people who have a mobile phone may want to download the Digital Health Passport.
• It is an App for children and young people with long term health conditions like asthma.
• It helps both you and them monitor their symptoms, gives information and advice and can even remind them to take their medication.
• You can also upload a copy of your child’s Personalised Asthma Action Plan so that they can show your doctor / nurse / teacher when needed.



• Ensure your child has a Personalised Asthma Action Plan and that this is shared with school.
• Ensure your child has their reliever and spacer in school, that it is in date and replaced when needed.
• Ensure you have given consent for your child to use the school emergency inhaler if required.


• Ensure your child takes their preventer medication every day as prescribed, using the correct technique (even if they seem well).
• You can contact your GP /Practice Nurse / School Nurse for further advice and support around your child’s asthma.
• Keep up to date with your childs annual asthma

• Supporting Children's Health and Young People with Asthma (educatio nforhealth.org
) – Tier 1 training
• Asthma Lung UK - Asthma + Lung UK (asthmaandlung.org.uk)
• Monkey Wellbeing - Asthma - Monkey Wellbeing


